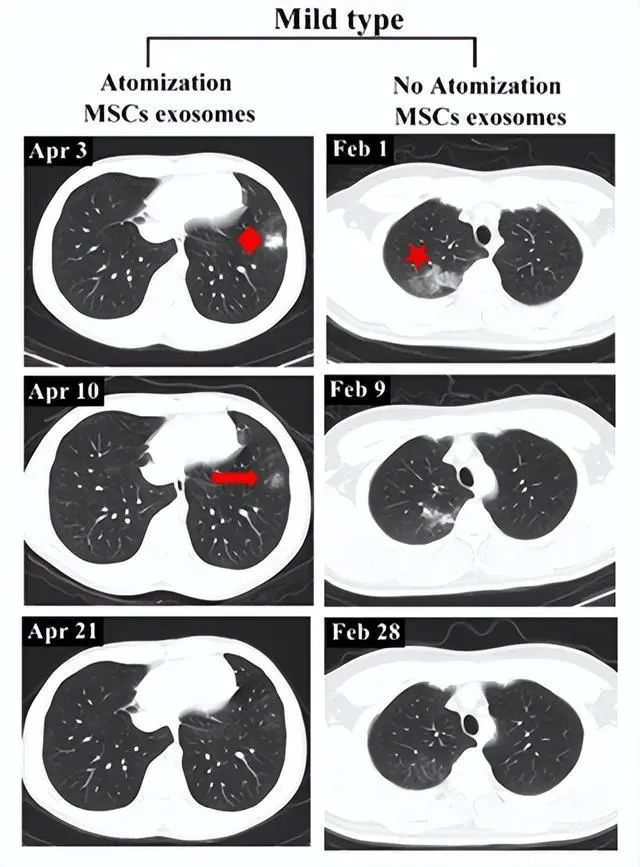
国务院联防联控新闻发布会：干细胞可以有效降低新冠病毒在患者体内引发的剧烈炎症反应

国务院联防联控新闻发布会:干细胞可以有效降低新冠病毒在患者体内引发的剧烈炎症反应
标签:
国务院联防联控机制新闻发布会上,国家科技部生物中心主任张新民答记者问中讲到,干细胞可以有效将低新冠病毒在患者体内引发的巨烈炎症反应,减少肺损伤,改善肺功能,对肺部进行保护和修复,对于减轻患者的肺纤维化具有积极作用。利用干细胞开展对危重型患者的临床研究及救治,结果显示,干细胞治疗安全、有效。能够使重症、危重症患者呼吸困难迅速得到缓解或者停止加重,在临床表现呼吸功能影像检查等方面均实现好转,一般8-10天可以达到治愈水平。
干细胞对于肺纤维化进程的阻断以及促进肺部损伤的修复作用,显示其对于防止肺纤维化改善患者远期愈后具有独特的优势。
之前,江苏省无锡市第五人民医院的临床研究证实脐带间充质干细胞来源外泌体雾化治疗新冠肺炎安全可行。该研究于今年6月发表于《Stem Cell Reviews and Reports(干细胞评论和报告》杂志上(2022年影响因子6.692)。
此次间充质干细胞(MSCs)外泌体雾化治疗试验研究于2020年2月26日至2020年9月4日进行。
7名被诊断患有COVID-19肺炎的患者,包括2例重症病例(患者2和4)和5例轻度病例(患者1、3、5、6和7),均纳入了研究(见下图)。

▲MSC衍生外泌体雾化处理时间表的流程图
患者1、2、3、4在抗病毒治疗一段时间后,对MSCs来源的外泌体进行了雾化治疗。
患者1为轻度病例,无任何基础疾病。患者2为重症,合并肝功能损害。
患者3为轻度病例,患者4为重症病例,均无基础疾病。
患者5,6和7从治疗开始就接受了MSCs来源的外泌体雾化治疗。
研究使用多个超滤步骤收集和纯化从MSCs分泌的外泌体。
图片▲MSCs分泌的外泌体的提取和鉴定
主要安全结果:
以往的大多数研究表明,MSCs来源的外泌体治疗肺部疾病是安全的,但给药途径是通常是通过静脉输注。此次试验结果表明,MSCs来源的外泌体的雾化治疗同样可以安全用于治疗肺部疾病。
雾化治疗后两小时内,所有患者均未观察到喉咙或舌头肿胀、皮疹发痒、呼吸急促、头晕、呕吐或低血压等急性过敏反应。治疗后也没有观察到继发性过敏反应。未报告不良事件。
疗效结果:
胸部CT检查表明,MSC来源外泌体的雾化治疗促进了肺部病变的吸收。
轻度病例前后影像变化:以患者6为例,2020年4月3日,该患者第一次CT扫描显示左肺下叶外有孤立结节,4月4日,患者接受外泌体雾化治疗,4月10日,第二次CT检查显示左肺下叶结节密度明显降低,大小也缩小,4月21日,第三次CT检查,左下肺病灶完全吸收,从发现结节到完全吸收肺部病变所需的时间为18天。
相比之下,另一例患者(轻度病例,无雾化治疗)类似肺部病变的吸收时间为27天。

▲左:患者6;右:无外泌体雾化治疗的轻度病例
重度患者前后影像变化:以患者2为例,该患者从2020年2月27日开始接受外泌体治疗,3月18日,患者的CT扫描显示双肺病变明显吸收,病变密度消退。4月1日,该患者肺部病灶完全吸收。
而未接受外泌体治疗的重度患者,吸收肺病灶后仍然存在纤维脐带阴影。
▲左:患者2;右:无外泌体雾化治疗的重度病例
其他五名患者的CT图像如下图所示,能发现从一开始就接受外泌体治疗的人(患者5、7)和抗病毒治疗一段时间后再接受外泌体治疗的人(患者1、3、4)在肺部病变完全吸收的时间之间存在显著差异。

▲患者 1、3、4、5 和 7 的胸部 CT 图像
外泌体是所有细胞产生的胞外小泡,携带核酸、蛋白质、脂质和代谢物,同时外泌体具有将miRNA递送到其他细胞的固有靶向能力,可作为细胞之间物质和信号通讯的途径。
外泌体的功能作用归因于分泌它的细胞。MSCs分泌的外泌体携带了IL-10 mRNA、miR-126和miR-30b,它们可保护肺纤维化;同时还携带了各种免疫调节蛋白,包括血管生成素-1(Ang-1)和肝细胞生长因子(HGF),已知这两种蛋白质都能减轻动物模型中的肺损伤。
一般来说,药物雾化是治疗肺部疾病的有效方法。雾化的MSC来源的外泌体可以到达肺部的精细结构,如细支气管和肺泡,以直接将抗炎分子递送到它们的靶位。
雾化吸入MSC来源外泌体不会诱发急性过敏反应或继发性过敏反应,同时促进肺部病变的吸收,并减少轻度新冠肺炎肺炎患者的住院时间。
总的来说,整个临床研究结果表明,雾化吸入间充质干细胞来源外泌体作为一种安全可行的新的方法用于治疗新冠肺炎肺炎,并且,该治疗办法不仅仅对新冠肺炎重症有效,对轻症同样也有效。
更重要的是如果在感染的早期阶段,就对患者进行雾化治疗MSC来源外泌体可能更有益。


